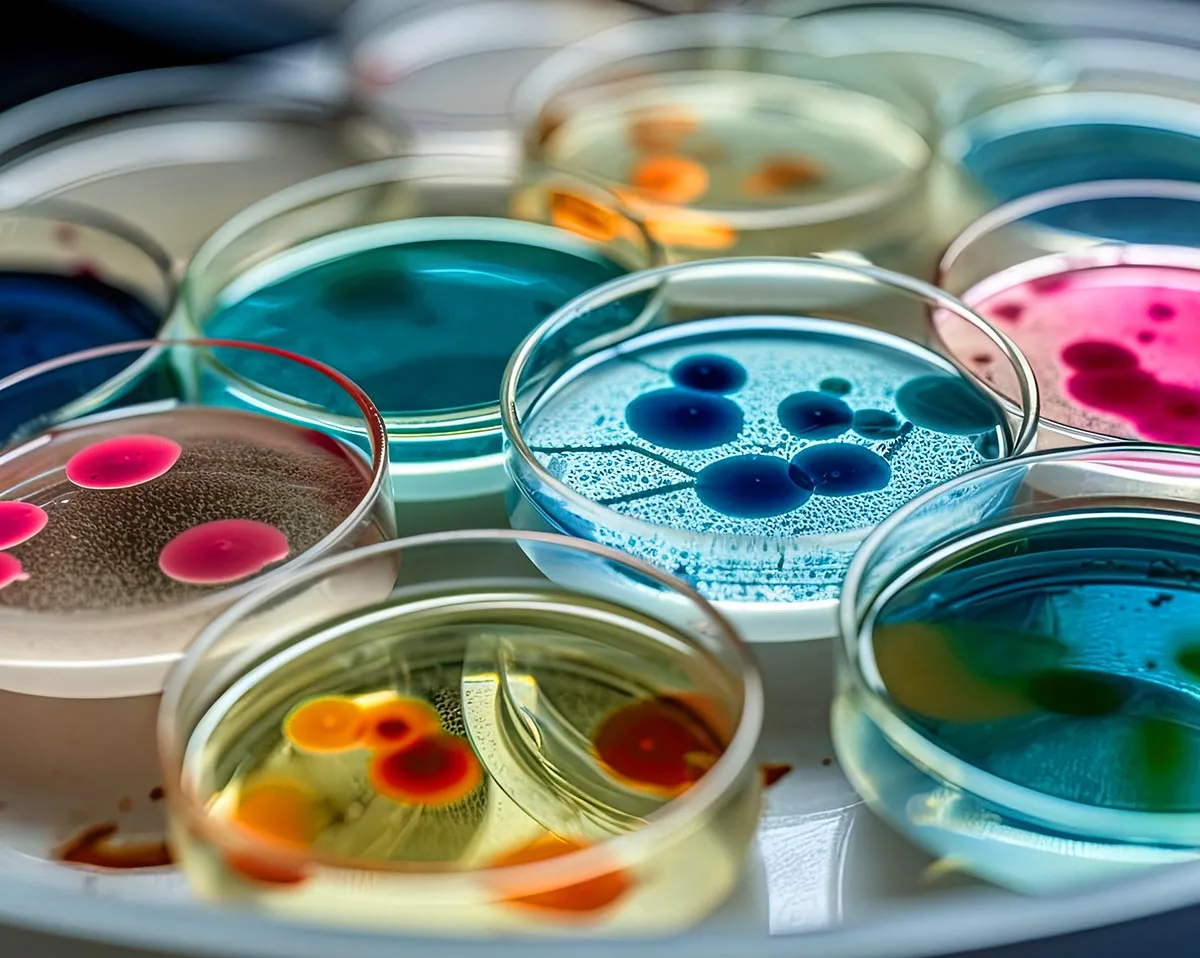

Explore Our Courses
The Fall 2026 application is now closed. The next opportunity to apply to take classes with UF Dual Enrollment will be for the upcoming Spring 2027 semester. Please stay tuned to our website for details on the Spring 2027 application cycle starting in September 2026.
Are you looking for an academic challenge?
Click each of the courses below to learn about goals and general education requirements.
Our college-level courses are 100% online and are created and taught by top UF professors and instructors.
Use the UF Dual Enrollment Course Crosswalk for a bird’s eye view of our course offerings.

ADV 3001–Advertising Strategy
Gen Ed Credit: Elective

AEB 2014 – Economic Issues, Food and You
Gen Ed Credit: Social Science

ANT 2000 – General Anthropology
Gen Ed Credit: Social Science

ANT 2140 – Introduction to World Archeology
Gen Ed Credit: Elective

ANT 2410 – Cultural Anthropology
Gen Ed Credit: Elective

ARC 1720 – Survey of Architectural History
Gen Ed Credit: Humanities, International

ARH 2000 – Art Appreciation: American Diversity and Global Arts
Gen Ed Credit: Humanities

AST 1002 – Discovering the Universe
Gen Ed Credit: Physical Science

BSC 2005 – Biological Sciences for Non-Majors
Gen Ed Credit: Biological Science

BSC 2460 – Can We Design “Better” Humans?
Gen Ed Credit: International

CHM 1020 – Chemistry for Liberal Arts
Gen Ed Credit: Physical Science

CHM 1025 – Introduction to Chemistry
Gen Ed Credit: Physical Science

CLP 3144 – Abnormal Psychology
Gen Ed Credit: Social Science

COP 3502 – Programming Fundamentals 1
Gen Ed Credit: Elective

COP 3503 – Programming Fundamentals 2
Gen Ed Credit: Elective

COP 3530 – Data Structures and Algorithms
Gen Ed Credit: Elective

COT 3100 – Applications of Discrete Structures
Gen Ed Credit: Elective

DEP 3053 – Developmental Psychology
Gen Ed Credit: Elective

ECO 2013 – Principles of Macroeconomics
Gen Ed Credit: Social Science

EEL 3872 – AI Fundamentals
Gen Ed Credit: Elective

EEX 2000 – Impact of Disabilities: Home, Community and Workplace
Gen Ed Credit: Elective

EGS 1006 – Introduction to Engineering
Gen Ed Credit: Elective

ENC 1101 – Expository and Argumentative Writing
Gen Ed Credit: Composition

ENC 1102 – Argument and Persuasion
Gen Ed Credit: Composition

Fall Only
ENY 2040 – The Insects
Gen Ed Credit: Biological Science

ESC 1000 – Introduction to Earth Science
Gen Ed Credit: Physical Science

EVR 2001 – Introduction to Environmental Science
Gen Ed Credit: International, Physical Science

FOS 2001 – Man’s Food
Gen Ed Credit: Biological Science, International

GEA 1000 – Geography of a Changing World
Gen Ed Credit: Biological Science, International

GEO 2242 – Extreme Weather
Gen Ed Credit: Physical Science

GLY 1102 – Age of Dinosaurs
Gen Ed Credit: Biological Science, Physical Science

GLY 1880 – Earthquakes, Volcanoes, and Other Hazards
Gen Ed Credit: Physical Science

HSC 2103 – Personal & Family Health
Gen Ed Credit: Social Science

Fall Only
IDS 1703 – Frontiers of Artificial Intelligence (AI)
Gen Ed Credit: Elective

LEI 2181 — Leisure Contemporary Society
Gen Ed Credit: Behavioral Science, Social Science

LIT 2000 – Introduction to Literature
Gen Ed Credit: Humanities

MAC 1105 – College Algebra
Gen Ed Credit: Mathematics

MAC 1114 – Trigonometry
Gen Ed Credit: Mathematics

MAC 1140 – Precalculus Algebra
Gen Ed Credit: Mathematics

MAC 1147 – Precalculus: Algebra and Trigonometry
Gen Ed Credit: Mathematics

MAC 2233 – Survey of Calculus I
Gen Ed Credit: Mathematics

MAC 2311 – Analytic Geometry and Calculus I
Gen Ed Credit: Mathematics

MAC 2312 – Analytic Geometry and Calculus II
Gen Ed Credit: Mathematics

MAC 2313 – Analytic Geometry and Calculus III
Gen Ed Credit: Mathematics

MAP 2302 – Differential Equations
Gen Ed Credit: Mathematics

MAS 3114 – Computational and Linear Algebra
Gen Ed Credit: Elective
MCB 2000 – Microbiology
Gen Ed Credit: Biological Science

MUL 2010 – Experiencing Music
Gen Ed Credit: Humanities, International

PHY 2020 – Introduction to Principles of Physics
Gen Ed Credit: Physical Science

Fall Only
POL 1130 – Introduction to Polish Language and Culture
Gen Ed Credit: Elective

PSY 2012 – General Psychology
Gen Ed Credit: Behavioral Science, Social Science

PUR 3000 – Public Relations Principles
Gen Ed Credit: Elective

Spring Only
REL 2121 – American Religious History
Gen Ed Credit: Diversity, Humanities

Fall Only
REL 2300 – Introduction to World Religions
Gen Ed Credit: Humanities, International

REL 3191 – Death and the Afterlife in World Religions
Gen Ed Credit: Elective

RTV 3001 – Introduction to Media Industries
Gen Ed Credit: Elective

SPM 2000 – Introduction to Sports Management
Gen Ed Credit: Elective

SPN 1130 – Beginning Spanish I
Gen Ed Credit: Elective

SPN1131 –Beginning Spanish II
Gen Ed Credit: Elective

STA 2023 – Introduction to Statistics 1
Gen Ed Credit: Mathematics

THE 2000 – Theatre Appreciation
Gen Ed Credit: Diversity, Humanities

WIS 2040 – Wildlife Issues
Gen Ed Credit: Biological Science

WIS 2552 – Biodiversity Conservation: Global Perspectives
Gen Ed Credit: Biological Science, International

WST 2322 – Introduction to Health Disparities
Gen Ed Credit: Elective